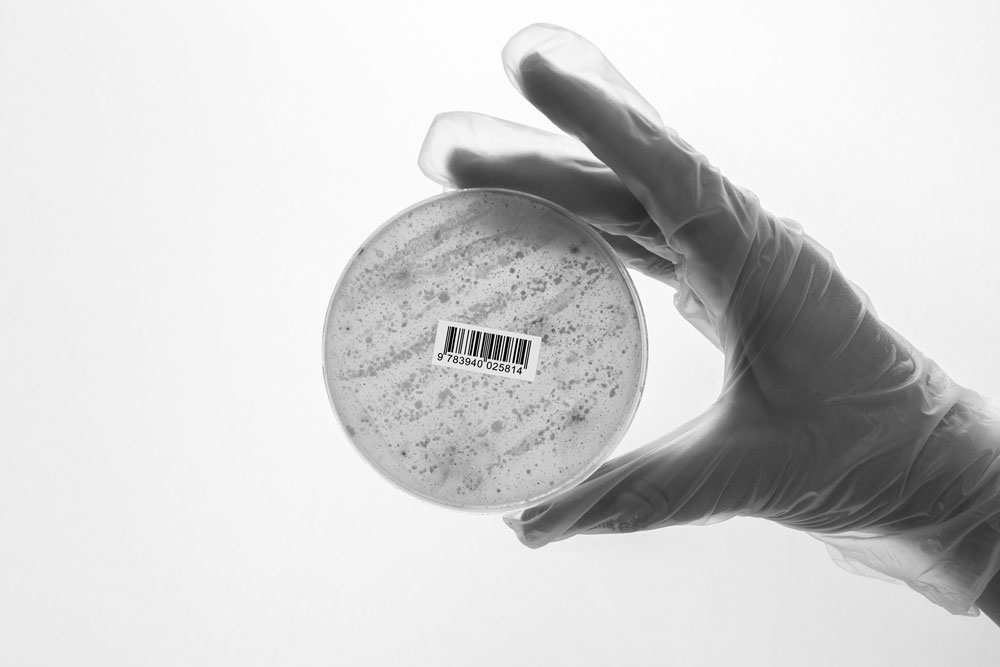
Eine behandschuhte Hand hält eine runde Petrischale vor einem hellen Hintergrund. Auf der leicht getrübten Oberfläche der Schale ist ein kleiner Barcode-Aufkleber angebracht.

Aus Korn wird Kapital – wirtschaftliche und politische Interessen rund um Gentechnik
Gentechnologien entstehen nicht im luftleeren Raum. Ihre Entwicklung und ihre Anwendung in der Landwirtschaft sind geprägt von Wirtschaftsinteressen und globalen Machtverhältnissen. Wie groß ist die Macht der Agrarkonzerne über das Saatgut? Drängt nun das Silicon Valley dazwischen? Welche Folgen hat der Anbau von Gentechnik-Pflanzen für Kleinbäuer*innen in Ländern des Globalen Südens? Und welche alternativen Ansätze gibt es?
GID MAGAZIN – Gen-ethischer Informationsdienst Nr. 275,
November 2025 vom 25.11.2025 / 41. Jahrgang, ISSN 2941-1084.
Redaktion: Laura Theuer (lt) (ViSdP), Judith Düesberg (jd), Isabelle Bartram (ib), Sasha Kirsten Achtelik (ska), Jonte Lindemann (jl)
Kooperation mit biorespect: Gabriele Pichlhofer (gp), Tino Plümecke (tp)
Gestaltung: Agnes Raguse
Titelbild: Agnes Raguse / Fotomanipulation mit Freepik Pikaso / Stockmaterial: Freepik